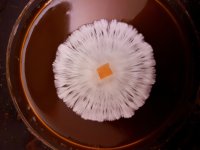
20190713_033411.jpg
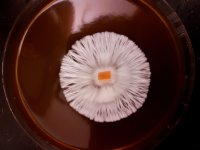
20190713_033330.jpg

spore syringe:
using spore syringes are relatively simple, i would just use them to inoculate 0.5kg spawn jars or bags and fruit them in a smaller box to sample tissue from the fruit stems on agar, but you can just continue taking spore prints from fruits and making more spore syringes and grow your mushrooms that way and it works, just stick with 0.5 to 1 kg spawn and colonize larger spawn bags with master grain (aka smaller colonized spawn) to prevent contamination
Agar:
1- Bring 1 liter of reverse osmosis or spring water to a boil
2- Add 30g light malt extract (you could also use filtered grain water from your spawn cook) + 3g nutritional yeast extract + 2g activated carbon (optional but makes for easier contamination recognition)
3- Slowly add 30g of agar/liter and stir until fully dissolved
4- Pour the agar medium to fill half of autoclave glass bottles (has a plastic screwed lid) or mason jars with a cotton filled hole and sterilize for 30 minutes at 15psi or 45 minutes in a home pressure cooker (open the de-pressure valve at a minimum and when the pressure inside your unit is the same as the room proceed to take the glasses out, fill 75% the volume of the glass MAX to prevent overflow)
5- Turn on your laminar flowhood about 30 minutes before pouring the agar in plates if it doesn’t come with an enclosed glass box to work in (the room should be closed off with positive pressure airflow from a hepafilter), Wear latex gloves and a breathing mask and sterilize your hands with 70% isopropyl-ethanol and lysol to ensure sterility
Let the solution cool to 60 Celsius and pour into agar plates in front of your laminar flow hood or Still Air Box, make sure to pour enough so that you fill half or more of the plate volume
6- Store the freshly poured plates in a clean wiped (with lysol and 70% isopropyl) box if your flowhood doesn't come with a glass box to ensure sterility while the plates cool and get ready for transfers
7- Use a scalpel and wipe it down with 75% isopropyl and flame sterilize it with a butane torch after the isopropyl evaporates (unless the blades come already sterilized) and let it cool before using it to transfer tissue from another plate or fruiting body or spore print
While transferring choose the healthy and rigorous sector of the mycelium and wrap the agar plate closed with breathable parafilm or micropore tape or other suitable materials to prevent contamination and water loss from the media
Colonize in 23C-27C (possible up to 30c but that stresses the mycelium over time and makes for more contaminations etc) and store the plates upside down in the fridge after
Liquid culture:
LC jars need a 2 micron filter patch or cotton filled holes and a silicone syringe port which you can make by using heat resistant silicone adhesives or just open the lid if you have a flowhood (make sure not to dent or bend lids and make perfect holes and ) and magnet bars (~3cm), make sure your jar or whatever you use has a properly fitting lid
Use 2g of light malt extract in 1L of reverse osmosis or spring water, fill about half of the jars (make sure to clean the jars if they were used with 20% bleach or lysol and isopropyl before using) with a magnetic bar (3cm) included and autoclave for 30 minutes at 15psi and colonize at 23C-27C and stir on fast on the magnetic stirrer for until tissue shreds everyday, use the lc or store in the fridge in a clean box before it gets too thick to suck up with a syringe, otherwise you can just pour it in your spawn instead of using a syringe
Autoclave the syringe and needle for 30m (unless they come already sterilized) and cool it in front of the flowhood/ in the still air box (i use a needle with a wider diameter to suck up a thicker LC as that helps alot with better colonization) and suck up the liquid culture and close the needle port and wrap with cellophane if you want to store it in the fridge for later, can also wrap the LC jar and store it in the fridge for later
Spawn (probably the most sensitive stage):
-i soak and rinse and strain with no cooking using organic millets with spring or tap water that's been sitting for a day for spawn bags (rinse completely until all dirt is gone before using) 1000g soaked millets + 1g gypsum in each spawn bag after my millets have absorbed all the water they can which usually takes less than 24h, i rinse to clean and strain them until all the extra water is gone and put them in spawn bags to sterilize in the autoclave, if i want to inject spores or liquid cultures or put in agar plates aka make master spawn bags, and then use 2kg and 3kg every time i do spawn to spawn in the bags to expand for more colonized spawn, this is the soak and no cook method with added gypsum after straining which has worked wonders for me
push all the air out if you're using spawn bags and wrap the bag over the spawn so it doesn't open back up before autoclaving (which vacuum seals your spawn automatically)
autoclave at 15 psi for 90 mins for 1 kg to 180 mins for 2 kg depending on the size of your spawn bags
Inject each 1kg spawn bag with about 3ml of thick LC in front of the flow hood (wipe the injection site with 70% iso and lysol or use a self healing injection port, you can also just open the top and pour in liquid cultures or agar wedges, tho if using spore syringe don't shake or move too much after injection to keep the spores in one place)
Colonize at 23C-27C and shake twice, once at about 20-30% colonization and again at about 60-70% for faster growth, if stalled also shake
Bulk substrate:
using straight cococoir or a coco+verm mix works and gives you good results, you can also use dried organic animal manure, coco coir can be soaked and rinsed to wash out any dirt if its not great quality, but in general you want to slowly add filtered or spring water in your substrate and mix it around until when you grab a handful and squeeze it hard you get around 20drops of water MAX, large vermiculite also helps with water retention later on
You should ideally use your sub right away, for smaller grows, you can find a large pot and submerge your bulk substrate bag with a weight underwater (and put something to stop the bag from touching the bottom of the pot) and bring the temp up to 85C and keep it there for 1.5 to 3 hours (longer for manure or ... hotter/nutrient rich material), and take it out to cool somewhere clean before you use it, for larger grows you have to create a large box or barrel pasteurizer which you can find on youtube, its actually not that complicated
fruiting box:
i use a monotub that has a lid which completely stops any air exchange, you can also use various other sorts of boxes, but consider good quality
4 holes each 2.5cm in diameter will be cut, each around the top corners of the monotub, while the spawn and bulk sub are colonizing it should be sealed off with non breathable tape, and when they are fruiting it should be replaced with micropore tape or filters
-wipe the tub Clean with 70% isopropyl and lysol and spread your garbage bag inside and also wipe your bags with 70% isopropyl and lysol and let it dry,spread your black garbage bag in the tub and mix the spawn and bulk substrate 1:2 layer by layer, start with the bulk and also finish with the bulk, don't let any grain be exposed to air on top and finish it to make up a total of 12-13 cm thickness, in front of the flow hood or somewhere with still clean air
close the lid and colonize at 23C-27C
Pinning:
after about 10 to 14 days or where mycelium has fully colonized tubs, slowly reduce the temp to 20c then replace the tapes with micropor, you also need a good amount of white light to hit the surface directly at least a 6 hours a day
Try to maintain temps at 20C-22C which makes for quality fruits
If surface is drying and no small water droplets can be seen spray pre boiled water at the walls of the tub and maintain humidity very high
Harvest:
before veils are opened (not while and not after) is a great time to harvest, concerning aesthetics and potency, fruit bodies can be taken from base of the stem, rotate clockwise and counter clockwise and pluck with ease, cut the bottoms and take them straight to the dryer
Tissue sampling:
-Take the apex fruit (which contains markers you desire) and in a sterile manner bring in the SAB or the hood, cut open with sterile blade (preferably use a tiny blade on a scalpel) and without damaging the tissue gently leave it on the agar dish and sterilize your scalpel again or have 2 ready at all times
taking tissue from different parts of the stem and cap produced different results, i'd like to isolate the most potent section of the mushroom which IME is just where the puff in base of the stem is ending)
-sectoring tissue from cloned agar plates is important, firstly if mycelium is growing puffy or dense , likely pH is not in the correct range, adding more agar (up to 30g/liter) can also improve mycelium integrity and health but is not a main factor of mycelial health
only sector the most healthy tissue from the plates and transfer for master cultures which will be used to expand more mycelium later
Drying:
using heat to dry the mushrooms will be detrimental to their potency and looks, use a dryer without a heat element, within 24h these should be cracker dry, its also important to seal them in vacuum bags with some dehydrating bags straight from the drier to maintain potency and long storage, store in room temp rather than fridge or freezer away from light
Sporework:
-if you have a print, scrape some on the middle of your agar plates (i usually try 6 but you can do more or less with your respective situation) and wait for mycelium to grow, two types of fast and vigorous growth can be spotted as potential fruiters one is a rhizomorphic section and a tomentose section, try to isolate the best tissue on the growth away from the spore drop point to avoid isolating multiple strains
-After isolation on a new agar plate you should see if you isolated a singular tissue based on how it grows and should proceed to spawn both types of mycelium and fruit them in a small box, this is usually to speed up the process of reaching a tissue clone from fruit stem so first we make sure our mycelium fruits and second we don't waste time and resources
-Usually cloning the best fruit from clusters after pinning results in a uniform and strong mycelium, 5 times cloning from fruit is usually the time to take a new spore print just in case the mycelium starts mutating or degenerating, usually when you repeat the process of spore work and fruit tissue work a total of 5-6 cycles your mushrooms look and act significantly different compared to the starting spore batch, this is also the method used to domesticate (whatever that means) wild mushrooms, and mixing different spores on agar and moving on with the process can result in crossing stable genetics, so this concludes general sporework for the home grower
using spore syringes are relatively simple, i would just use them to inoculate 0.5kg spawn jars or bags and fruit them in a smaller box to sample tissue from the fruit stems on agar, but you can just continue taking spore prints from fruits and making more spore syringes and grow your mushrooms that way and it works, just stick with 0.5 to 1 kg spawn and colonize larger spawn bags with master grain (aka smaller colonized spawn) to prevent contamination
Agar:
1- Bring 1 liter of reverse osmosis or spring water to a boil
2- Add 30g light malt extract (you could also use filtered grain water from your spawn cook) + 3g nutritional yeast extract + 2g activated carbon (optional but makes for easier contamination recognition)
3- Slowly add 30g of agar/liter and stir until fully dissolved
4- Pour the agar medium to fill half of autoclave glass bottles (has a plastic screwed lid) or mason jars with a cotton filled hole and sterilize for 30 minutes at 15psi or 45 minutes in a home pressure cooker (open the de-pressure valve at a minimum and when the pressure inside your unit is the same as the room proceed to take the glasses out, fill 75% the volume of the glass MAX to prevent overflow)
5- Turn on your laminar flowhood about 30 minutes before pouring the agar in plates if it doesn’t come with an enclosed glass box to work in (the room should be closed off with positive pressure airflow from a hepafilter), Wear latex gloves and a breathing mask and sterilize your hands with 70% isopropyl-ethanol and lysol to ensure sterility
Let the solution cool to 60 Celsius and pour into agar plates in front of your laminar flow hood or Still Air Box, make sure to pour enough so that you fill half or more of the plate volume
6- Store the freshly poured plates in a clean wiped (with lysol and 70% isopropyl) box if your flowhood doesn't come with a glass box to ensure sterility while the plates cool and get ready for transfers
7- Use a scalpel and wipe it down with 75% isopropyl and flame sterilize it with a butane torch after the isopropyl evaporates (unless the blades come already sterilized) and let it cool before using it to transfer tissue from another plate or fruiting body or spore print
While transferring choose the healthy and rigorous sector of the mycelium and wrap the agar plate closed with breathable parafilm or micropore tape or other suitable materials to prevent contamination and water loss from the media
Colonize in 23C-27C (possible up to 30c but that stresses the mycelium over time and makes for more contaminations etc) and store the plates upside down in the fridge after
Liquid culture:
LC jars need a 2 micron filter patch or cotton filled holes and a silicone syringe port which you can make by using heat resistant silicone adhesives or just open the lid if you have a flowhood (make sure not to dent or bend lids and make perfect holes and ) and magnet bars (~3cm), make sure your jar or whatever you use has a properly fitting lid
Use 2g of light malt extract in 1L of reverse osmosis or spring water, fill about half of the jars (make sure to clean the jars if they were used with 20% bleach or lysol and isopropyl before using) with a magnetic bar (3cm) included and autoclave for 30 minutes at 15psi and colonize at 23C-27C and stir on fast on the magnetic stirrer for until tissue shreds everyday, use the lc or store in the fridge in a clean box before it gets too thick to suck up with a syringe, otherwise you can just pour it in your spawn instead of using a syringe
Autoclave the syringe and needle for 30m (unless they come already sterilized) and cool it in front of the flowhood/ in the still air box (i use a needle with a wider diameter to suck up a thicker LC as that helps alot with better colonization) and suck up the liquid culture and close the needle port and wrap with cellophane if you want to store it in the fridge for later, can also wrap the LC jar and store it in the fridge for later
Spawn (probably the most sensitive stage):
-i soak and rinse and strain with no cooking using organic millets with spring or tap water that's been sitting for a day for spawn bags (rinse completely until all dirt is gone before using) 1000g soaked millets + 1g gypsum in each spawn bag after my millets have absorbed all the water they can which usually takes less than 24h, i rinse to clean and strain them until all the extra water is gone and put them in spawn bags to sterilize in the autoclave, if i want to inject spores or liquid cultures or put in agar plates aka make master spawn bags, and then use 2kg and 3kg every time i do spawn to spawn in the bags to expand for more colonized spawn, this is the soak and no cook method with added gypsum after straining which has worked wonders for me
push all the air out if you're using spawn bags and wrap the bag over the spawn so it doesn't open back up before autoclaving (which vacuum seals your spawn automatically)
autoclave at 15 psi for 90 mins for 1 kg to 180 mins for 2 kg depending on the size of your spawn bags
Inject each 1kg spawn bag with about 3ml of thick LC in front of the flow hood (wipe the injection site with 70% iso and lysol or use a self healing injection port, you can also just open the top and pour in liquid cultures or agar wedges, tho if using spore syringe don't shake or move too much after injection to keep the spores in one place)
Colonize at 23C-27C and shake twice, once at about 20-30% colonization and again at about 60-70% for faster growth, if stalled also shake
Bulk substrate:
using straight cococoir or a coco+verm mix works and gives you good results, you can also use dried organic animal manure, coco coir can be soaked and rinsed to wash out any dirt if its not great quality, but in general you want to slowly add filtered or spring water in your substrate and mix it around until when you grab a handful and squeeze it hard you get around 20drops of water MAX, large vermiculite also helps with water retention later on
You should ideally use your sub right away, for smaller grows, you can find a large pot and submerge your bulk substrate bag with a weight underwater (and put something to stop the bag from touching the bottom of the pot) and bring the temp up to 85C and keep it there for 1.5 to 3 hours (longer for manure or ... hotter/nutrient rich material), and take it out to cool somewhere clean before you use it, for larger grows you have to create a large box or barrel pasteurizer which you can find on youtube, its actually not that complicated
fruiting box:
i use a monotub that has a lid which completely stops any air exchange, you can also use various other sorts of boxes, but consider good quality
4 holes each 2.5cm in diameter will be cut, each around the top corners of the monotub, while the spawn and bulk sub are colonizing it should be sealed off with non breathable tape, and when they are fruiting it should be replaced with micropore tape or filters
-wipe the tub Clean with 70% isopropyl and lysol and spread your garbage bag inside and also wipe your bags with 70% isopropyl and lysol and let it dry,spread your black garbage bag in the tub and mix the spawn and bulk substrate 1:2 layer by layer, start with the bulk and also finish with the bulk, don't let any grain be exposed to air on top and finish it to make up a total of 12-13 cm thickness, in front of the flow hood or somewhere with still clean air
close the lid and colonize at 23C-27C
Pinning:
after about 10 to 14 days or where mycelium has fully colonized tubs, slowly reduce the temp to 20c then replace the tapes with micropor, you also need a good amount of white light to hit the surface directly at least a 6 hours a day
Try to maintain temps at 20C-22C which makes for quality fruits
If surface is drying and no small water droplets can be seen spray pre boiled water at the walls of the tub and maintain humidity very high
Harvest:
before veils are opened (not while and not after) is a great time to harvest, concerning aesthetics and potency, fruit bodies can be taken from base of the stem, rotate clockwise and counter clockwise and pluck with ease, cut the bottoms and take them straight to the dryer
Tissue sampling:
-Take the apex fruit (which contains markers you desire) and in a sterile manner bring in the SAB or the hood, cut open with sterile blade (preferably use a tiny blade on a scalpel) and without damaging the tissue gently leave it on the agar dish and sterilize your scalpel again or have 2 ready at all times
taking tissue from different parts of the stem and cap produced different results, i'd like to isolate the most potent section of the mushroom which IME is just where the puff in base of the stem is ending)
-sectoring tissue from cloned agar plates is important, firstly if mycelium is growing puffy or dense , likely pH is not in the correct range, adding more agar (up to 30g/liter) can also improve mycelium integrity and health but is not a main factor of mycelial health
only sector the most healthy tissue from the plates and transfer for master cultures which will be used to expand more mycelium later
Drying:
using heat to dry the mushrooms will be detrimental to their potency and looks, use a dryer without a heat element, within 24h these should be cracker dry, its also important to seal them in vacuum bags with some dehydrating bags straight from the drier to maintain potency and long storage, store in room temp rather than fridge or freezer away from light
Sporework:
-if you have a print, scrape some on the middle of your agar plates (i usually try 6 but you can do more or less with your respective situation) and wait for mycelium to grow, two types of fast and vigorous growth can be spotted as potential fruiters one is a rhizomorphic section and a tomentose section, try to isolate the best tissue on the growth away from the spore drop point to avoid isolating multiple strains
-After isolation on a new agar plate you should see if you isolated a singular tissue based on how it grows and should proceed to spawn both types of mycelium and fruit them in a small box, this is usually to speed up the process of reaching a tissue clone from fruit stem so first we make sure our mycelium fruits and second we don't waste time and resources
-Usually cloning the best fruit from clusters after pinning results in a uniform and strong mycelium, 5 times cloning from fruit is usually the time to take a new spore print just in case the mycelium starts mutating or degenerating, usually when you repeat the process of spore work and fruit tissue work a total of 5-6 cycles your mushrooms look and act significantly different compared to the starting spore batch, this is also the method used to domesticate (whatever that means) wild mushrooms, and mixing different spores on agar and moving on with the process can result in crossing stable genetics, so this concludes general sporework for the home grower
Dedicated to the mushroom and all of its patrons
Attachments
-
 20190713_032944.jpg3.4 MB · Views: 10
20190713_032944.jpg3.4 MB · Views: 10 -
 IMG_2646.JPG5.1 MB · Views: 10
IMG_2646.JPG5.1 MB · Views: 10 -
 IMG_2712.JPG5.6 MB · Views: 11
IMG_2712.JPG5.6 MB · Views: 11 -
 IMG_2804.JPG4.4 MB · Views: 8
IMG_2804.JPG4.4 MB · Views: 8 -
 IMG_2766.JPG3.8 MB · Views: 6
IMG_2766.JPG3.8 MB · Views: 6 -
 IMG_2721.JPG4.4 MB · Views: 7
IMG_2721.JPG4.4 MB · Views: 7 -
 20200301_203817.jpg4.5 MB · Views: 10
20200301_203817.jpg4.5 MB · Views: 10 -
 20190904_101707.jpg3.3 MB · Views: 10
20190904_101707.jpg3.3 MB · Views: 10 -
 20190830_104217.jpg3 MB · Views: 10
20190830_104217.jpg3 MB · Views: 10 -
 20190830_154248.jpg4.8 MB · Views: 9
20190830_154248.jpg4.8 MB · Views: 9 -
 20190822_074342.jpg4.3 MB · Views: 10
20190822_074342.jpg4.3 MB · Views: 10 -
20190713_033411.jpg4.3 MB · Views: 6
20190713_033411.jpg4.3 MB · Views: 6 -
20190713_033330.jpg4.3 MB · Views: 8
20190713_033330.jpg4.3 MB · Views: 8




